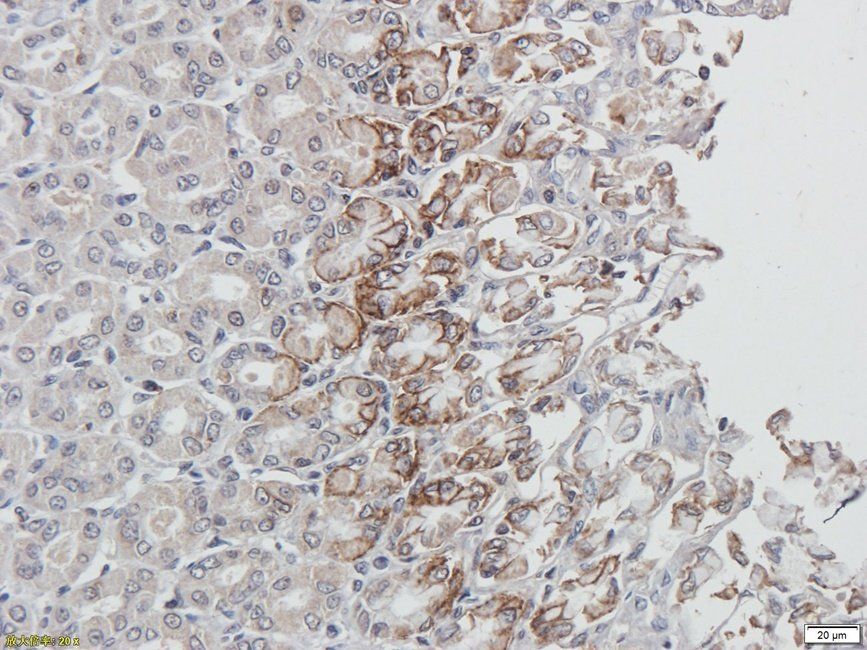
产品细节图片2
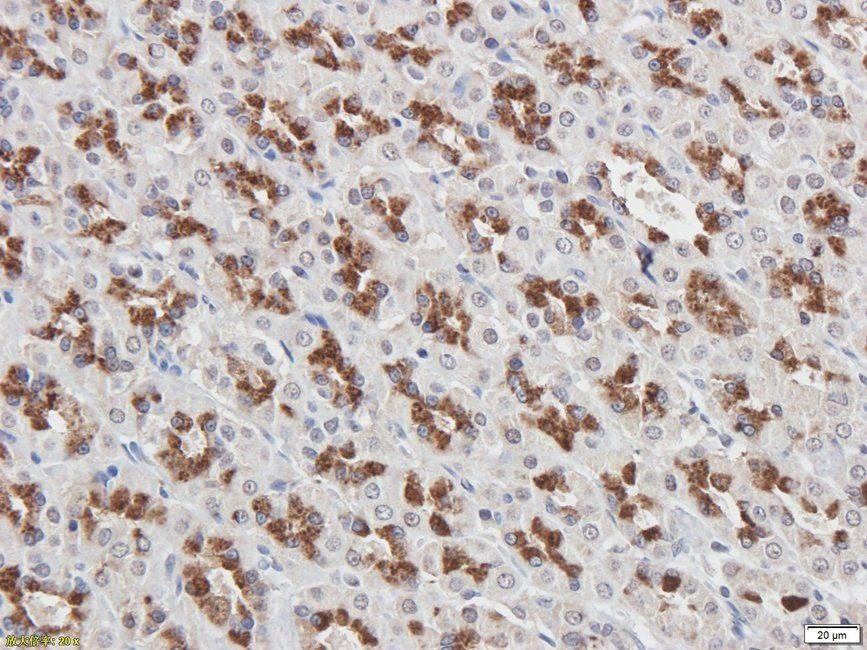
产品细节图片4
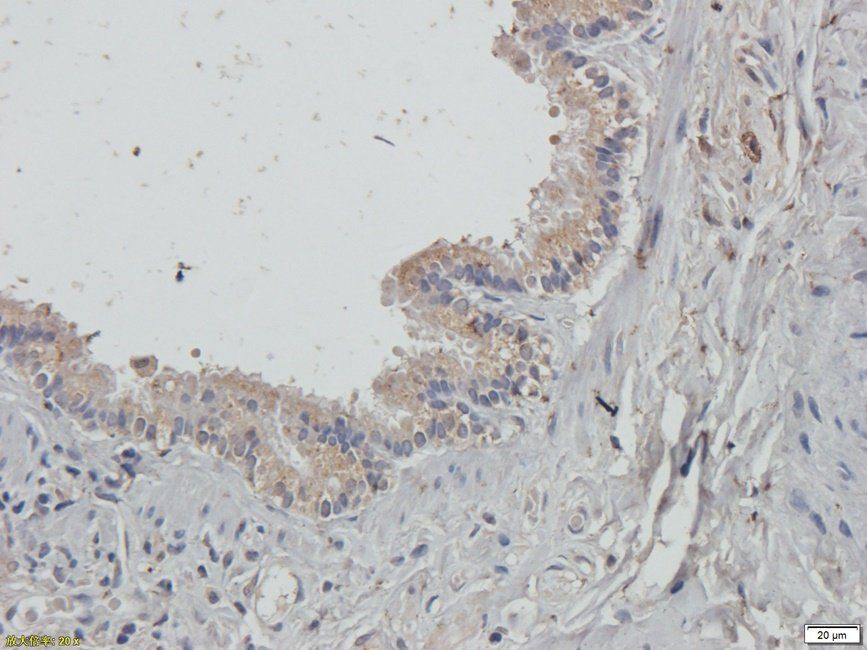
产品细节图片7

相关产品推荐更多 >
万千商家帮你免费找货
0 人在求购买到急需产品
- 详细信息
- 文献和实验
- 技术资料
- 抗体名:
Guanylate Cyclase beta1 subunit antibody抗体
- 抗体英文名:
Guanylate Cyclase beta1 subunit antibody
- 靶点:
Guanylate Cyclase beta1 subunit
- 浓度:
- 100 μg (in 200 μl): 0.5 mg/ml- 200 μg (in 400 μl): 0.5 mg/ml
- 应用范围:
ICC, IF, IHC-P, WB
- 宿主:
Rabbit
- 适应物种:
Human, Mouse, Rat
- 保质期:
6-12个月
- 抗原来源:
详询
- 目录编号:
orb55865
- 级别:
科研级
- 库存:
88
- 供应商:
biorbyt
- 标记物:
Unconjugated
- 克隆性:
Polyclonal
- 形态:
10 mM PBS, 0.02% sodium azide
- 亚型:
IgG
- 免疫原:
KLH conjugated synthetic peptide derived from human Guanylate Cyclase beta1 subunit. Please contact us for the exact immunogen sequence. The peptide is available as orb393998.
- 规格:
100 ug
别名:anti-MARCO antibody, anti-SCARA2 antibody, anti-Scavenger receptor class A member 2.
免疫原:KLH conjugated synthetic peptide derived from human Guanylate Cyclase beta1 subunit. Please contact us for the exact 免疫原 sequence. The peptide is available as orb393998.
分子量:53 kDa
应用稀释比例:WB: 1-200-2000, IHC-P: 1:100-500, IF/ICC: 1/100-500
纯度:Polyclonal antibodies are purified by peptide affinity chromatography
保存说明:Maintain refrigerated at 2-8°C for up to 2 weeks. For long term storage store at -20°C in small aliquots to prevent freeze-thaw cycles.
NCBI:006761, 006770
Entrez:8685
UniProt ID:Q02153
Note:For research use only.

风险提示:丁香通仅作为第三方平台,为商家信息发布提供平台空间。用户咨询产品时请注意保护个人信息及财产安全,合理判断,谨慎选购商品,商家和用户对交易行为负责。对于医疗器械类产品,请先查证核实企业经营资质和医疗器械产品注册证情况。
文献和实验[资源] 所有的看家基因(housekeeping genes)列表+引物设计服务
protein), beta 1, 88kDa (CTNNB1), mRNA 1165 NM_003753 Homo sapiens eukaryotic translation initiation factor 3, subunit 7 zeta, 66/67kDa (EIF3S7), mRNA 1363 NM_004541 Homo sapiens NADH dehydrogenase (ubiquinone) 1 alpha subcomplex, 1, 7.5kDa (NDUFA1
GeneRIF: Data suggest that heme and heme oxygenase-1 regulate soluble guanylate cyclase through mechanisms involving nitric oxide and carbon monoxide. REFERENCE 47 (bases 1 to 1600) AUTHORS Colombrita,C., Calabrese,V., Stella,A.M., Mattei,F., Alkon,D.L
技术资料暂无技术资料 索取技术资料











